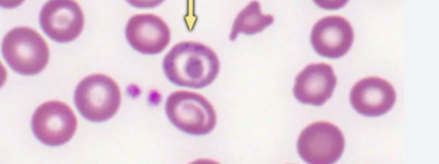

[] is the intervention of choice for severe mitral stenosis
Percutaneous mitral commissurotomy is the intervention of choice for severe mitral stenosis

A patient is waiting for PCI.
They are within 2hrs of a PCI centre / in a PCI centre.
What is the longest time they can wait from symptom onset before considering alternative to PCI treatment?
within 12 hours of symptom onset and within 2 hours of medical contact
If patients present more than 12 hours of symptom onset, pharmacotherapy should be the management of choice provided they are asymptomatic and stable
A mammogram typically shows a star or rosette-shaped lesion with a translucent centre AND asymptomatic with no evidence of lumps = ?
Radial scar
- A radial scar is a benign breast condition which can mimic a breast carcinoma. It describes idiopathic sclerosing hyperplasia of the breast ducts
What are contraindications to thrombolysis for PCI? [+]
Aortic Dissection
GI bleed
Allergic reaction
Iatrogenic: recent surgery
Neurological disease: recent stroke (within 3 months), malignancy
Severe HTN (>200/120)
Trauma, including recent CPR
Label the side effects


What platelet levels indicate a transfusion in a normal patient? [no ongoing bleeding]? [1]
A threshold of 10 x 109 except where platelet transfusion is contradindicated or there are alternative treatments for their condition
What are the platelet levels that would indicate a transfusion for patients with:
- a clinically significant bleeding risk
- severe bleeding from critical sites, such as CNS
Offer platelet transfusions to patients with a platelet count of < 30 x 10 9 with clinically significant bleeding (World Health organisation bleeding grade 2- e.g. haematemesis, melaena, prolonged epistaxis)
Platelet thresholds for transfusion are higher (maximum < 100 x 10 9) for patients with severe bleeding (World Health organisation bleeding grades 3&4), or bleeding at critical sites, such as the CNS.
What causes this change? [1]
What FBC would you expect to see with this? [2]
Sideroblastic anaemia is a condition where red cells fail to completely form haem, whose biosynthesis takes place partly in the mitochondrion:
- hypochromic microcytic anaemia
- high ferritin iron & transferrin saturation
Infective endocarditis infection with Strep bovis indicates which further investigations? [1]
Why? [1]
Colonoscopy
- important link with colorectal cancer. Need to consider colonoscopy and biopsy in these patients.
Patient with suspected IE.
ECG recording reveals new PR interval length to be increased.
What is the next appropriate treatment? [1]
The newly lengthened PR interval (1st degree heart block) suggests peri-valvular abscess as a complication of infective endocarditis - indicates need for valve replacement
History of subacute infective endocarditis x acute abdominal pain = ?
Infective endocarditis caused acute mesenteric ischaemia
Common exam question: PR interval prolongation in a patient with Infective Endocarditis is an indication for [] as it can be secondary to []
Common exam question: PR interval prolongation in a patient with Infective Endocarditis is an indication for surgery as it can be secondary to aortic root abscess
Which of the following types of renal stones are radio-lucent?
Triple phosphate stones
Cystine stones
Calcium phosphate
Xanthine stones
Calcium oxalate
Which of the following types of renal stones are radio-lucent?
Triple phosphate stones
Cystine stones
Calcium phosphate
Xanthine stones
Calcium oxalate
cystine stones: semi-opaque
urate + xanthine stones: radio-lucent
If it helps, I just remember that the stones at the back of the alphabet are radio-lucent - Urate and Xanthine :) and then cystine being semi-opaque is just a weird one to rote learn
You believe he has Balanitis Xerotica Obliterans. What can be associated with this condition?
Protection from cancer
Phimosis
Protection from infection
Prostate hyperplasia
Basal cell carcinoma
You believe he has Balanitis Xerotica Obliterans. What can be associated with this condition?
Protection from cancer
Phimosis
Protection from infection
Prostate hyperplasia
Basal cell carcinoma

Describe how changes in potassium relate to digoxin toxicity [2]
Hypokalemia increases the risk of digoxin toxicity by facilitating binding to the sodium-potassium ATPase pump, and in turn, digoxin toxicity can lead to hyperkalemia due to excessive pump inhibition
What is the first line management for persistent pneumothorax?
First-line management is with surgical pleurodesis.
his patient has several signs of chronic (high-pressure) retention: >1L retention volume, abnormal renal profile and possibly postobstructive diuresis (>200 mL/h).
How do you manage this patient? [1]
Leave the catheter in situ
- These patients should not have a trial without catheter (TWOC) as it can further exacerbate renal impairment. Instead, they should have a long term catheter until further specialist review with regards to the underlying cause
How do you treat WPW? [1]
definitive treatment: radiofrequency ablation of the accessory pathway
medical therapy: sotalol, amiodarone, flecainide
sotalol should be avoided if there is coexistent atrial fibrillation as prolonging the refractory period at the AV node may increase the rate of transmission through the accessory pathway, increasing the ventricular rate and potentially deteriorating into ventricular fibrillation
Anal fissures are normally located in which position?
More than 90% of anal fissures are located in the posterior midline of the anal canal. There is evidence that circulation here is poor and anal spasms further reduce blood supply.

What can you use to reverse digoxin toxicity? [1]
DigiFab or Digibind are digoxin specific antibodies used in digoxin toxicity to neutralise free digoxin
What are the symptoms of digoxin toxicity? [+]
dizziness, nausea and vomiting, palpitations, bradycardia, visual disturbances, confusion, and hyperkalaemia.

What is the MoA of digoxin? [1]
Inhibiting the Na+ K+ ATPase enzyme, also known as the sodium-potassium pump. This causes sodium to build up inside the heart cells, decreasing the ability of the sodium-calcium exchanger to push calcium out of the cells, consequently causing calcium to build up in the sarcoplasmic reticulum.
Increased intracellular calcium results in a positive inotropic effect, which in turn has the effect of increasing the force of the heart’s contractions.

Patient has heart failure and presents with:
* Yellow-green colour disturbance
* Visual haloes
* Confusion
what is your first differential? [1]
Digoxin toxicity
A person has SVT.
What pathology would be a contraindication to giving them adenosine? [1]
What would you give instead? [1]
Asthma - instead give them verapamil














